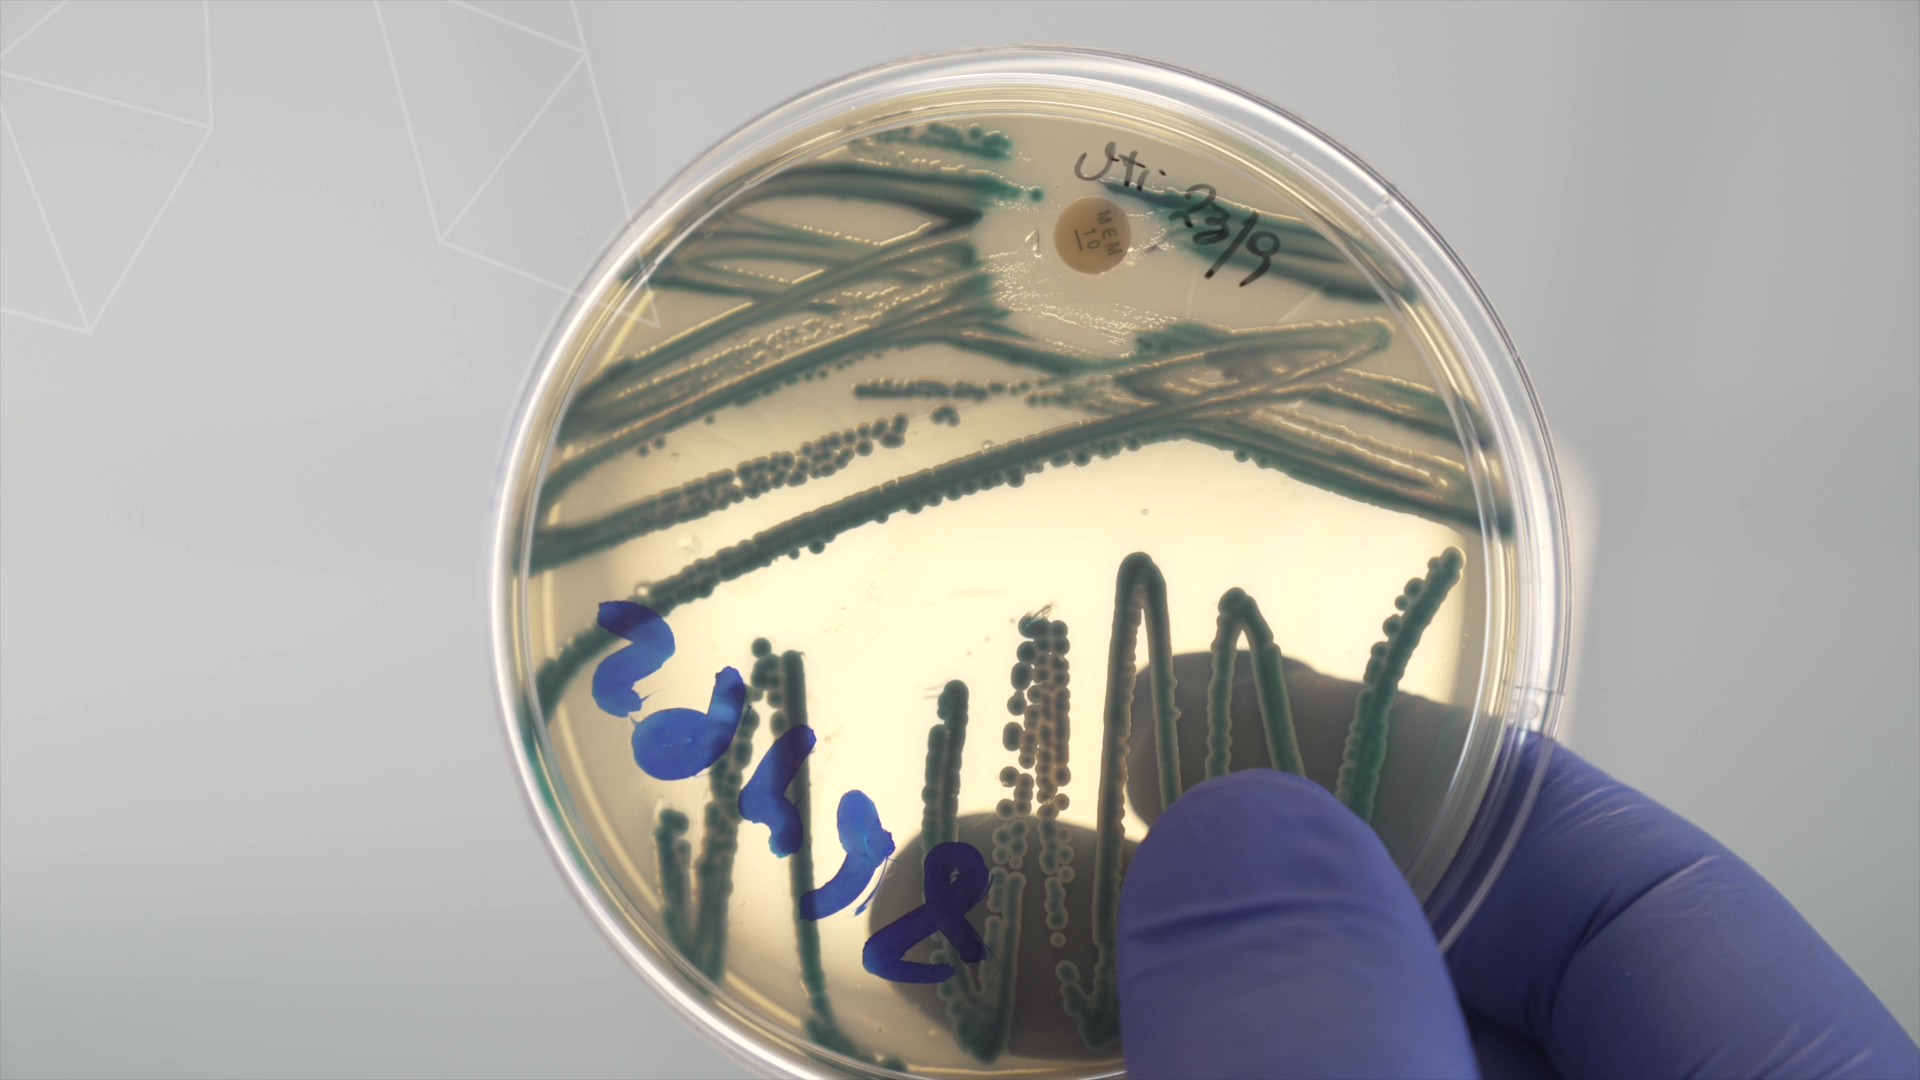

Una edición especial para celebrar la innovación
10 proyectos que marcan la diferencia y dejan
huella en la innovación uruguaya.
Conocé sus historias y descubrí su impacto.

Un dispositivo sin pantalla que enseña matemática a niños a través del juego, pensado para escuelas sin conectividad, diseñado desde Uruguay para el mundo.

Desarrollaron una vacuna contra la garrapata bovina con un 90% de efectividad inicial, una innovación clave para el sector agropecuario y la salud animal en Uruguay.

Desarrolla fármacos innovadores para tratar enfermedades como la obesidad, la diabetes tipo 2, las enfermedades metabólicas, neurodegenerativas y autoinmunes.

Preservan la fertilidad de niñas y mujeres sometidas a tratamientos oncológicos, combinando medicina reproductiva, investigación y un compromiso profundo con la calidad de vida futura.

Combina biotecnología y propósito humano para desarrollar terapias virales que atacan tumores sin dañar células sanas.
Desarrollan tratamientos personalizados basados en bacteriófagos, una alternativa innovadora frente a la resistencia a los antibióticos.

Crearon un biopolímero a partir de una bacteria antártica que absorbe líquidos, con potencial de transformar sectores como la higiene y la agricultura.

Primera plataforma que enseña Lengua de Señas Uruguaya con inteligencia artificial. Accesible, interactiva y diseñada para romper barreras comunicacionales desde cualquier celular.

Una plataforma digital que mide el bienestar emocional de los estudiantes. Permite detectar a tiempo señales de alarma como aislamiento o bullying y acompañar mejor a cada alumno.

Impulsan un modelo de ganadería regenerativa que preserva ecosistemas únicos, reduce huella de carbono y refuerza la imagen de Uruguay como productor sustentable en los mercados globales.